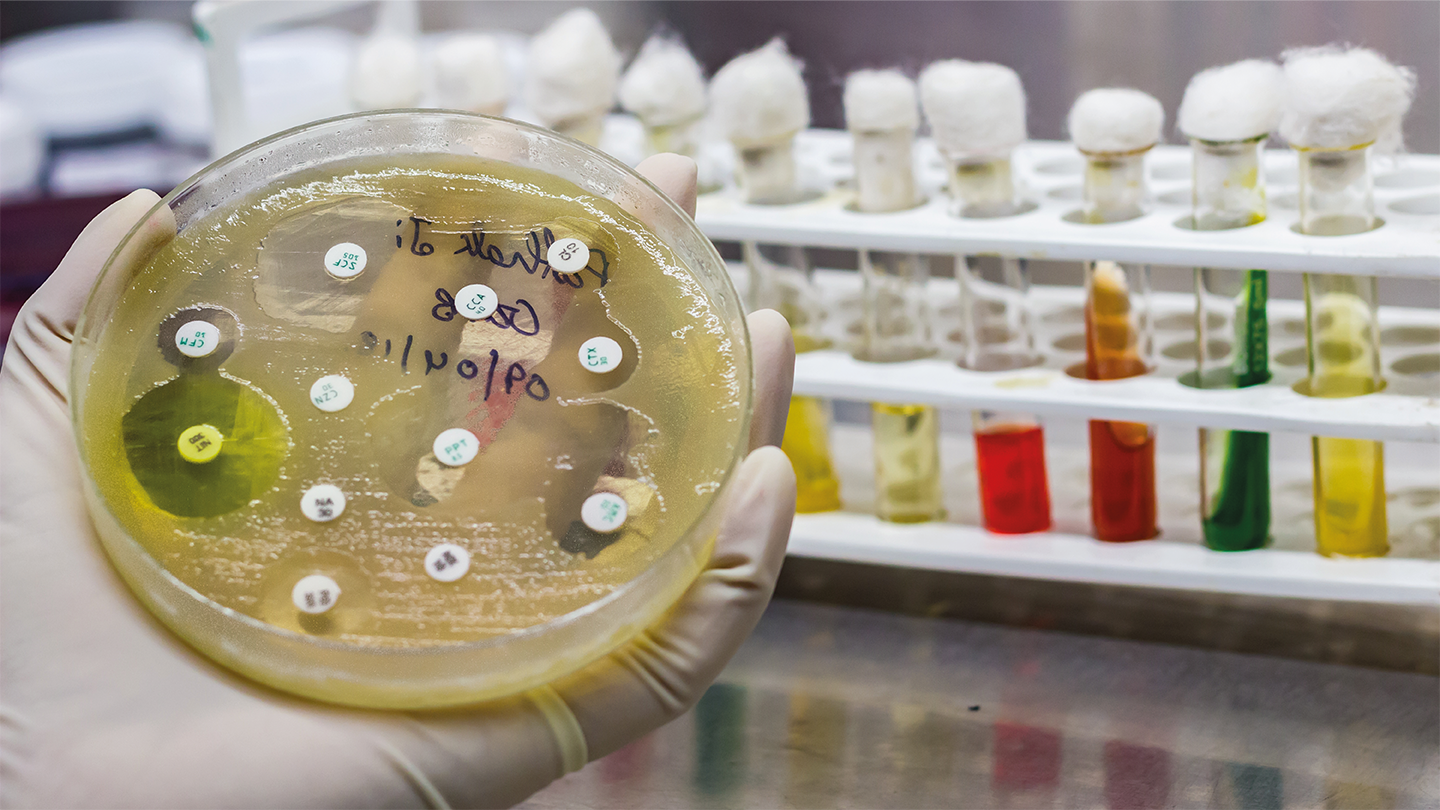

A new study has shed light on how antibiotic resistance genes (ARGs) spread between bacteria, revealing the key roles played by genetic compatibility and shared environments. The findings could help researchers better predict – and potentially disrupt – the transfer of resistance genes to harmful pathogens.
Antibiotic resistance often arises when bacteria acquire ARGs from other microbes via horizontal gene transfer – a process distinct from the slower accumulation of mutations. This exchange of genetic material allows resistance to jump between distantly related bacterial species, speeding the rise of multi-drug-resistant infections. However, the factors that govern which bacteria can share these genes – and in what settings – have remained unclear.
In the latest research, scientists at Chalmers University of Technology in Sweden analyzed nearly one million bacterial genomes to identify 6,276 clear cases of ARG transfer between different bacterial orders. They then linked this genomic data with more than 20,000 metagenomic samples from diverse environments – including human, animal, soil, water, and wastewater microbiomes – and used machine learning to identify the features that made such transfers more or less likely.
The results showed that genetic compatibility between donor and recipient bacteria was crucial. “Most resistance genes are shared between bacteria with a similar genetic structure. We believe that this reduces the cost of taking up new genes. We are continuing the research to understand the mechanisms that control this process more precisely,” said corresponding author Erik Kristiansson.
Environmental context also played a major role. ARG transfers were most frequent in human-associated and wastewater microbiomes, where different bacteria are more likely to live in close quarters and antibiotic exposure is common. Transfers were especially common in the gut and on the skin, and within wastewater systems. Soil and aquatic environments showed less evidence of active ARG transfer, possibly due to lower co-occurrence of the bacterial species involved.
By combining genetic and ecological data, the team’s models could predict ARG transfers with high accuracy – offering a potential roadmap for surveillance and intervention. The work underscores the importance of the “One Health” approach to antimicrobial resistance, considering human, environmental, and microbial factors together. As the spread of resistance continues to threaten treatment options, better forecasting tools may prove crucial in the global effort to preserve antibiotic effectiveness.
